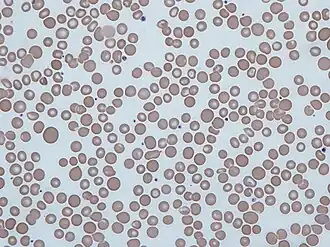
Мазок крови содержащей эритроциты различного размера

Анизоцитоз
| Анизоцитоз | |
|---|---|
![]() Мазок крови содержащей эритроциты различного размера | |
| МКБ-10 | R71 |
| МКБ-9 | 790.09 |
| DiseasesDB | 725 |
Анизоцитоз (ширина распределения эритроцитов) — патологическое состояние, при котором происходит изменение размеров эритроцитов. В среднем размер нормальных эритроцитов (нормоцитов) в крови варьирует в пределах от 7 до 7,5 мкм. Микроциты характеризуются величиной до 6,9 мкм. Макроциты и мегалоциты имеют размер от 8 мкм и от 12 мкм, соответственно. В крови здорового человека содержание нормоцитов не превышает 70 % от всего объёма, тогда как на долю микроцитов и макроцитов приходится до 15 %. Изменение этого соотношения, которое может быть определено анализом крови, указывает на развитие анизоцитоза. Клинические симптомы анизоцитоза сходны с анемией или сердечной недостаточностью и характеризуются быстрой утомляемостью, упадком сил, учащённым сердцебиением и одышкой. Среди причин, приводящих к анизоцитозу, выделяют недостаток витамина A или B12, железа, миелодиспластический синдром и онкологические патологии крови с метастазами в костном мозгу. Лечение анизоцитоза, как правило, сводится к устранению причины его появления.
Литература
- Г. И. Назаренко, А. А. Кишкун, «Клиническая оценка результатов лабораторных исследований», г. Москва, 2005 г.